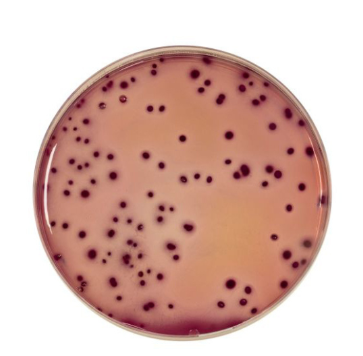

-
Interchema
Verpakkingseenheid: 250ML
Artikelnummer: I-E6.213.62A
Reguliere prijs €23,67Eenheid prijsOp voorraad -
Interchema
Verpakkingseenheid: 25GR
Artikelnummer: I-A2.210.025
Reguliere prijs €37,20Eenheid prijsOp voorraad -
Boom
Verpakkingseenheid: 500GR
Artikelnummer: I-A6.113.68A
Reguliere prijs €19,56Eenheid prijsOp voorraad -
Condalab
Violet Red Bile Agar With Lactose (VRBL) ISO
Verpakkingseenheid: 500GR
Artikelnummer: M.1093
Reguliere prijs €70,82Eenheid prijsOp voorraad -
Interchema
Vleesextract, poeder (eenheid 43 gram)
Verpakkingseenheid: 100GR
Artikelnummer: I-Z9.306.70A
Reguliere prijsVan €47,05Eenheid prijsOp voorraad -
Hanna
Vloeibare reagentia voor Vrije Chloor-0
Verpakkingseenheid: 300ST
Artikelnummer: 490452
Reguliere prijs €37,00Eenheid prijsOp voorraad -
Condalab
Verpakkingseenheid: 500GR
Artikelnummer: M.1092
Reguliere prijs €71,79Eenheid prijsOp voorraad -
Tritium
Verpakkingseenheid: 250ML
Artikelnummer: M.V010.76.0250
Reguliere prijs €23,32Eenheid prijsOp voorraad